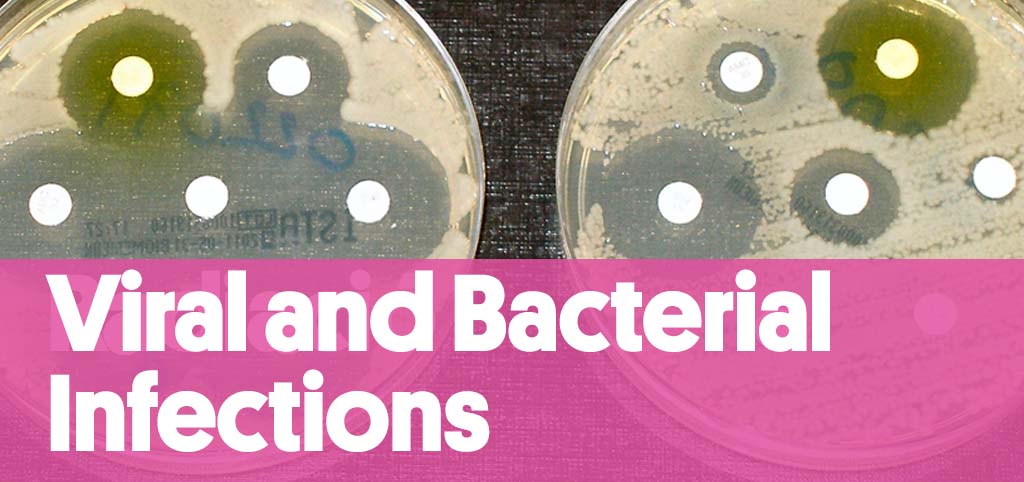

El nostre lloc web www.isglobal.org (el “Lloc Web”) utilitza una tecnologia denominada “cookies” amb la finalitat de poder recollir informació sobre l’ús del Lloc Web.
Una cookie és un arxiu que es descarrega al seu equip (ordinador o dispositiu mòbil) amb la finalitat d’emmagatzemar dades que podran ser actualitzades i recuperades per l’entitat responsable de la seva instal·lació.
La informació aconseguida a través de les cookies pot incloure la data i l’hora de visites al Lloc Web, les pàgines vistes, el temps que ha passat al nostre Lloc Web i els llocs visitats just abans i just després d’aquest.
L’informem que podem utilitzar cookies amb la finalitat de facilitar la seva navegació pel Lloc Web, proporcionar-li una millor experiència en navegar-hi, distingir-lo d’altres usuaris, i identificar problemes amb la finalitat de millorar el Lloc Web. Així mateix, en cas que vostè atorgui el seu consentiment, utilitzarem cookies que ens permetin obtenir més informació sobre les seves preferències i personalitzar el Lloc Web, d’acord amb els seus interessos individuals.
La present política de cookies té la finalitat d’informar-lo de manera clara i precisa sobre les cookies que s’utilitzen al nostre Lloc Web (la “Política de Cookies”). En cas que vulgui obtenir més informació sobre les cookies que utilitzem al Lloc Web, podrà enviar un correu electrònic a l’adreça següent: lopd@isglobal.org.
Tipus de cookies que s’utilitzen al Lloc Web
El nostre lloc web utiliza les cookies que es descriuen tot seguit:
Cookies pròpies
Són les cookies que s’envien al seu ordinador i es gestionen exclusivament per nosaltres amb la finalitat d’assolir un millor funcionament del Lloc Web. La informació que recollim es fa servir per millorar la qualitat del nostre servei i la seva experiència com a usuari. Aquestes cookies romanen al seu navegador més temps, i ens permeten reconèixer-lo com a visitant periòdic del Lloc Web i adaptar-ne el contingut per poder oferir-li continguts que s’ajustin a les seves preferències.
Cookies analítiques de tercers
Si interactua amb el contingut del nostre Lloc Web, també poden establir-se cookies de tercers (per exemple, en prémer botons de xarxes socials o reproduir vídeos allotjats en un altre lloc web). Les cookies de tercers són les establertes per un domini diferent del nostre Lloc Web. No podem accedir a les dades emmagatzemades a les cookies d’altres llocs web quan navegui als llocs web en qüestió.
Al nostre Lloc Web utilitzem el sistema de mesura d’audiència Google Analytics, Facebook, First Party, Twitter, Vimeo, Youtube, Instagram, Issuu y Opinion Stage. Aquestes eines ens permeten conèixer com interactuen els usuaris del nostre Lloc Web. Les cookies emprades es consideren “persistents”, és a dir que les dades continuen emmagatzemades al terminal i, per tant, el responsable de la cookie pot accedir-hi i pot tractar-les durant un període definit que pot anar d’uns minuts a diversos anys.
Tot seguit, classifiquem les cookies segons la finalitat per la qual es tractin les dades obtingudes:
- Cookies tècniques: permeten, a l’usuari, navegar a través d’una pàgina web, plataforma o aplicació, i l’ús de les diferents opcions o serveis que s’hi hagin habilitat, com ara controlar el trànsit i la comunicació de dades, identificar la sessió, accedir a parts d’accés restringit, recordar els elements que integren una comanda, realitzar el procés de compra d’una comanda, realitzar la sol·licitud d’inscripció o participació en un esdeveniment, utilitzar elements de seguretat durant la navegació, emmagatzemar continguts per difondre vídeos o so, o compartir continguts a través de les xarxes socials.
- Cookies de personalització: permeten, a l’usuari, accedir al servei amb algunes característiques de caràcter general predefinides d’acord amb una sèrie de criteris al terminal de l’usuari, per exemple l’idioma, el tipus de navegador a través del qual accedeix al servei, la configuració regional des d’on s’accedeix al servei, etc.
- Cookies d’anàlisi: permeten, al responsable d’aquestes, el seguiment i l’anàlisi del comportament dels usuaris dels llocs web als quals estan vinculades. La informació recollida mitjançant aquest tipus de cookies s’empra per mesurar l’activitat dels llocs web, aplicació o plataforma, i per elaborar perfils de navegació dels usuaris d’aquests llocs web, aplicacions i plataformes amb la finalitat d’introduir millores a partir de l’anàlisi de les dades d’ús que fan els usuaris del servei.
- Cookies publicitàries: permeten la gestió dels espais publicitaris de la manera més eficaç possible.
- Cookies de publicitat comportamental: emmagatzemen informació del comportament dels usuaris obtinguda a través de l’observació continuada dels seus hàbits de navegació, la qual cosa permet desenvolupar un perfil específic per mostrar publicitat d’acord amb aquest perfil.
- Cookies de xarxes socials externes: s’utilitzen amb la finalitat que els visitants puguin interactuar amb el contingut de diverses plataformes socials (Facebook, YouTube, Twitter, LinkedIn, etc.) i es generin únicament per als usuaris d’aquestes xarxes socials. Les condicions d’ús d’aquestes cookies i la informació compilada es regula per la política de privacitat de la plataforma social corresponent.
Aquestes cookies, juntament amb els nostres arxius de registre del servidor, ens permeten conèixer el nombre total d’usuaris que visiten el Lloc Web i les parts del Lloc Web que gaudeixen d’una major popularitat. Gràcies a aquestes cookies obtenim una informació que pot ajudar-nos a millorar la navegació i brindar un millor servei a usuaris i clients.
Facilitem, tot seguit, un enllaç al lloc web de Google on pot consultar la descripció del tipus de cookies que utilitza Google Analytics i el seu període d’expiració.
Consentiment
En navegar i continuar al nostre Lloc Web estarà consentint l’ús de les cookies abans mencionades, pels terminis indicats i en les condicions contingudes en aquesta Política de Cookies.
Deshabilitar y bloquejar cookies
Com que les cookies no són necessàries per a l’ús del nostre Lloc Web, l’informem que pot bloquejar-les o deshabilitar-les a través de la configuració del seu navegador que li permet rebutjar la instal·lació de totes les cookies o d’algunes. La majoria de navegadors permeten advertir la presència de cookies o rebutjar-les automàticament. Si les rebutja podrà seguir usant el nostre Lloc Web, encara que l’ús d’alguns dels seus serveis pot ser limitat i, per tant, la seva experiència al nostre Lloc Web pot resultar menys satisfactòria.
Revocar el meu consentiment
Si, en qualsevol moment, volgués revocar el seu consentiment relacionat amb aquesta Política de Cookies, haurà d’eliminar les cookies emmagatzemades al seu equip (ordinador o dispositiu mòbil) a través dels ajustos i configuracions del navegador d’Internet. Per a més informació sobre l’eliminació, deshabilitació o bloqueig de les cookies, li recomanem que visiti aquesta pàgina.
Modificació de la configuració i ajustos sobre cookies
Tret que hagi ajustat la configuració del seu navegador, el nostre sistema crearà cookies així que visiti el nostre Lloc Web. Tingui present que tots els navegadors d’Internet permeten el canvi d’aquesta configuració. Per a més informació sobre la manera d’ajustar les configuracions de cookies als següents navegadors, el remetem a l’enllaç pertinent:
Internet Explorer:
Canvis en la Política de Cookies
És possible que actualitzem la Política de Cookies del nostre Lloc Web. Per això, recomanem que revisi aquesta política cada cop que accedeixi al nostre Lloc Web amb la finalitat d’estar adequadament informat/da sobre com i per a què usem les cookies. La Política de Cookies va actualitzar-se per darrera vegada a data del 11 de març de 2020.
Contacte
Si tingués cap dubte, comentari o suggeriment sobre la Política de Cookies, pot escriure a la persona Delegada de Protecció de Dades: lopd@isglobal.org.
[Actualitzat el 11 de març de 2020 · Foto: Christopher Burns / Unsplash]

 Jordi Vila Estapé Research Professor i director de la Iniciativa de Resistències Antimicrobianes
Jordi Vila Estapé Research Professor i director de la Iniciativa de Resistències Antimicrobianes